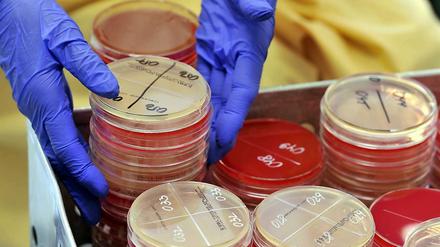
Bakterien, die gegen bestimmte Antibiotika resistent sind, werden durch diese nicht mehr gehemmt oder abgetötet.

Der griechische Finanzminister Gianis Varoufakis widerspricht Medienberichten, dass die Regierung eine parallele Währung zum Euro vorbereite. Die einzige Lösung der Krise sei eine politische.

Der griechische Finanzminister Gianis Varoufakis widerspricht Medienberichten, dass die Regierung eine parallele Währung zum Euro vorbereite. Die einzige Lösung der Krise sei eine politische.

Bei seinen Lesungen in der Schweiz hat sich unser Kolumnist Frank Willmann mal in der lokalen Fußballszene umgeschaut - und Walther White aus der Fernsehserie Breaking Bad auf der Trainerbank einer Fußballrebellenstadt entdeckt.

Die Helfer in Nepal graben weitere Tote aus. Und noch immer bebt die Erde. Viele Menschen leben seit 18 Tagen in Angst - ihre Gesundheit leidet. Ein Hubschrauber der US-Armee ist während eines Hilfseinsatzes verschwunden.
Das deutsche Fernsehen hat den Porno-Schock der Jahrtausendwende überstanden und sendet wieder ordentlich Sex. Doch das Internet droht die Programmmacher erneut zu überrumpeln.

Wenn der Trainer ruft, müssen die Fernsehmenschen warten: Oliver Welke und Oliver Kahn ist nach dem Champions-League-Aus der Bayern gegen Barcelona während des Live-Interviews im ZDF-Studio Bayern-Spieler Thomas Müller abhanden gekommen.
Schon mal Hirschpenis gegessen? Oder das "beste Stück" mit Qigong trainiert? Das ZDF hat einen Reporter losgeschickt, um den kuriosesten Mythen und Praktiken rund um die Manneskraft nachzugehen.

Reed Hastings setzt auf getrennte Rechnung: Netflix sorgt für Inhalte, Telekom-Unternehmen für Transport. Und lineares Fernsehen wird verschwinden

Verlage und andere Medienhäuser bringen zusammen mit Facebook komplette Artikel und Videos auf das Smartphone. Die Amerikaner bieten technisches Know-how und Werbe-Erlöse an.

Papst Franziskus hat in seiner wöchentlichen Generalaudienz gute Manieren in den Familien gefordert - mit einfachen Worten, die manchmal schwer umzusetzen sind. Damit berührt er Herzen. Wieder einmal. Ein Kommentar.

Der Regierende Bürgermeister Müller frühstückt mit Unternehmern, spricht über BER, ICC und die wachsende Stadt und räumt Fehler ein - beim Personalabbau im öffentlichen Dienst.

Seit der großen Wirtschaftskrise ist die Konjunktur das Sorgenkind der Ökonomen. Vor allem die sonst so robusten Schwellenländer schwächeln und zeigen nachhaltige Wachstumsschwierigkeiten. Nun holt überraschend Europa wieder langsam auf.

Kompromisslos, böse und immer noch gut: Die amerikanische Ur-Grunge-Band Mudhoney spielte im Berghain ein fulminantes Konzert.

Ein Kauf der insolventen Windfirma Prokon wäre für die EnBW ein Riesenschritt auf dem Weg zur Energiewende. Konzernchef Mastiaux rührt kräftig die Werbetrommel und hofft, dass ihm die Gläubiger nicht doch noch in die Suppe spucken.

Ein 65-Jähriger kommt nach Hause und findet auf seiner Couch einen betrunken Mann. In der Wohnung fehlen technische Geräte. Kurz darauf nimmt die Polizei zwei Verdächtige mit technischen Geräten fest. Und finden bei ihnen Teile der Beute.

Der Wutbürger mag keine Windräder. Nur wenn sie zehnmal so weit weg wie hoch sind, könne er damit leben, behauptet die bayerische Landesregierung. Alles Quatsch sagt nun eine Studie und nennt Zahlen. Die Bürger wollen nur beteiligt werden – finanziell und an der Diskussion.

Der Wassertourismus in der Region Potsdam-Berlin boomt. Die Binnenschifffahrt hält die zahlreichen Party-Boote und Flöße mit Grills aber für zu unsicher. Und fordert nun schärfere Auflagen.

Bei ihrer Forderung nach einer Freigabe von Marihuana bekommen die Grünen nun ausgerechnet von einem CDU-Abgeordneten Unterstützung. Dabei geht es auch um Steuereinnahmen, die ein staatlich regulierter Cannabis-Markt einbringen könnte. Gesundheitsminister Gröhe lehnt das weiterhin strikt ab.

Heute will EU-Kommissionschef Jean-Claude Juncker ein Quotensystem zur Verteilung von Flüchtlingen auf die EU-Mitgliedstaaten vorstellen. Wie sieht das neue System aus?

Schon mal Hirschpenis gegessen? Oder das "beste Stück" mit Qigong trainiert? Das ZDF hat einen Reporter losgeschickt, um den kuriosesten Mythen und Praktiken rund um die Manneskraft nachzugehen.

Der Bezirk hat das Bierkastenrennen am Vatertag untersagt. Hundefreunde wollen gegen Hundeverbot protestieren. Großer Stau auf dem Stadtring wegen des Besuchs des israelischen Staatspräsidenten. Lesen Sie im Liveticker, was am Mittwochmorgen in Berlin los war.

Er wäre das erste Mal öffentlich auf Martin Winterkorn getroffen, doch nun sagte Ferdinand Piëch seine Teilnahme an der Hauptversammlung der Porsche-Holding ab. Sein Kontrahent Winterkorn demonstriert Gelassenheit.

Ein Jahr lang haben die Kinder und Jugendlichen mit dem amerikanischen Komponisten Todd Fletcher gearbeitet, jetzt hat ihr Musical "Turbulence" Premiere. Für Tagesspiegel-Leser gibt es Karten.

Während die spanische Presse das Angriffstrio des FC Barcelona und Keeper Marc-André ter Stege feiert, attestieren die deutschen Medien dem FC Bayern München einen respektablen Abgang. Die Presseschau zum Champions-League-Halbfinale.

In Köln wurden neue öffentliche Toiletten aufgestellt. Das Urinal ist gratis, die Sitztoiletten kosten 50 Cent. In Köln begründet man diese Maßnahme mit der "Wildpinkler-Problematik".

Noch hat sich Nepal vom dem schweren Beben Ende April nicht erholt, da erschüttet ein weiterer Erdstoß die Himalayaregion. Allein in Nepal starben mehr als 50 Menschen. Unsere Korrespondentin wurde in Kathmandu während eines Interviews von dem Beben überrascht.

Die Haushaltssperre im Bezirk Steglitz-Zehlendorf trifft auch die Musikschullehrer: An der Leo-Borchard-Musikschule herrscht seit Anfang Januar ein Aufnahmestopp, für gekündigte Verträge bekommen die Lehrkräfte keine neuen Schüler. Gerade freiberufliche Musiklehrer sehen nun ihre berufliche Existenz bedroht.

Wieder Gewalt in Pakistan. Bei einem Angriff der Organisation Jundullah auf einen mit Schiiten besetzten Bus in Karachi sind mindestens 43 Menschen getötet worden.

31.000 gestohlene Fahrräder, die meisten in Pankow: Der Pirat Andreas Baum fordert mehr Ermittler – und "Köder"-Bikes, die Klauer anlocken sollen.

Reed Hastings setzt auf getrennte Rechnung: Netflix sorgt für Inhalte, Telekom-Unternehmen für Transport. Und lineares Fernsehen wird verschwinden
Hitze, Prügelei, Verfolgungsjagd: Die Mitglieder der Stuntmen-Crew im Filmpark Babelsberg haben Unterhosen getestet. Das Highlight war ein brennender Mann.

Vor den Spielen um den EHF-Pokal im Handball am Wochenende in Berlin drohen den Füchsen mehrere Ausfälle. Führungsspieler Iker Romero sieht dennoch gute Chancen auf den Titel für die Berliner.

Käsekuchen-Himbeere- und Erdnussbutter-Schinken-Eis gibt es bei Woop Woop Icecream. Doch das eigentlich Besondere: Das Eis wird erst vor den Augen der Kunden mit Stickstoff hergestellt und schockgefrostet.

Anfang des 20. Jahrhunderts begannen Homosexuelle, sich zu emanzipieren. Das Zentrum dieser Bewegung war Berlin: Hier blühten queerer Aktivismus, Forschung und Kultur – bis die NSDAP den Traum zerstörte. Ein Beitrag aus unserem neuen Queerspiegel.

Die Mutter kann es nicht fassen - der Tod ihrer Tochter auf Juist wird nicht als Mord geahndet. Dafür gebe es keine Anhaltspunkte, erklärt der Richter des Bundesgerichtshofs. Und weist auch die Revision des Täters zurück.

Es geht ein Riss durch die Berliner Philharmoniker, die sich selbst und ihre Unabhängigkeit gerne als Demokratie-Lehrstück ins Licht rücken. In der Debatte, wer Simon Rattle beerben könnte, verbirgt sich auch die Frage, wie stark sich Kunst eigentlich gesellschaftlich legitimieren muss. Ein Kommentar.

An Christi Himmelfahrt ziehen Gruppen von Männern um die Häuser. Sie grillen und trinken zum Vatertag, doch Vorsicht: Nicht alles ist erwünscht, nicht alles erlaubt. So manche kleine Ordnungswidrigkeit kann Geldstrafen von mehreren Tausend Euro nach sich ziehen.

Weil die Fahrradhersteller keine einheitliche Norm für Rahmengrößen anwenden, ist die Auswahl des passenden Modells gar nicht so leicht. Doch wer einige Regeln beherzigt und ein Auge auf die Geometrien hat, wird sein Traumrad finden.

Für Potsdam wird es immer schwieriger, die vorgeschriebene Schadstoffgrenze an der Zeppelinstraße und an der Großbeerenstraße zu unterbieten. Denn auch im April war dort die Schadstoffbelastung zu hoch. Geht es so weiter, drohen erhebliche Strafzahlungen.

Das Amtsgericht Charlottenburg kippt die bisherige Berechnung des Mietspiegels. Was bedeutet das für die Mieter? Lesen Sie hier eine Übersicht.
Klare Regeln für den Einsatz von Antibiotika in der Medizin und in der Tierhaltung: Dies steht im Mittelpunkt eines Gesetzentwurfs, den das Bundeskabinett am Mittwoch verabschiedet hat. Denn jedes Jahr sterben mehrere tausend Menschen an den Folgen von Antibiotika-Resistenzen.

Auch nach 15 Jahren noch fresh und innovativ: Die Pop-Schlaumeier von Hot Chip veröffentlichen mit „Why Make Sense?“ erneut ein gutes Album.

Alba Berlin hat das erste Play-off-Spiel gegen Oldenburg mit großem Einsatz in den Schlussminuten noch für sich entschieden. Im zweiten Spiel in Oldenburg dürfen sich die Berliner aber nicht allein auf den Kampfgeist verlassen.

Zwei maskierte Täter haben in der Nacht zu Mittwoch eine Spielothek in der Neuköllner Sonnenallee überfallen. Sie bedrohten einen Angestellten mit einem Elektroschocker.

"Ein geheimnisloser, kein unangenehmer Mensch": Wenn Udo Voigt, der für die NPD im Europa-Parlament sitzt, zwölf Magazinseiten in der Süddeutschen Zeitung kriegt. Ein Kommentar.

Ein Beben der Stärke 6,8 hat den Nordosten von Japan erschüttert - jene Region, die 2011 von einem gewaltigen Erdstoß und einem anschließenden Tsunami heimgesucht wurde.
Drei der fünf deutschen Beachvolleyball-Nationalteams geben beim Open-Turnier in Luzern ihr Jahres-Debüt auf der Welttour.
Nikita Kutscherow hat die Tampa Bay Lightning ins Playoff-Halbfinale der nordamerikanischen Eishockey-Profiliga NHL geführt.

Papi ist ein böser Mann: „Das Fest“ vom Schauspiel Stuttgart läuft beim Berliner Theatertreffen. Zwischenbilanz des Festivals: Ein Jahrgang, der gern aktuell, politisch, welthaltig sein will - was ihm nicht immer gelingt.
öffnet in neuem Tab oder Fenster